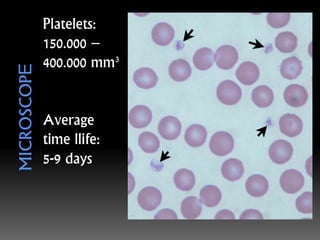
Platelets:
150.000 –
400.000 mm³
Average
time llife:
5-9 days

This document discusses alopecia (hair loss) and its various types and causes. It provides details on platelet rich plasma (PRP) therapy for treating alopecia, including how PRP is obtained from blood, how it contains growth factors, and the procedure for PRP injections into the scalp. A study treated 10 patients with androgenetic alopecia with monthly PRP injections over 3 months.